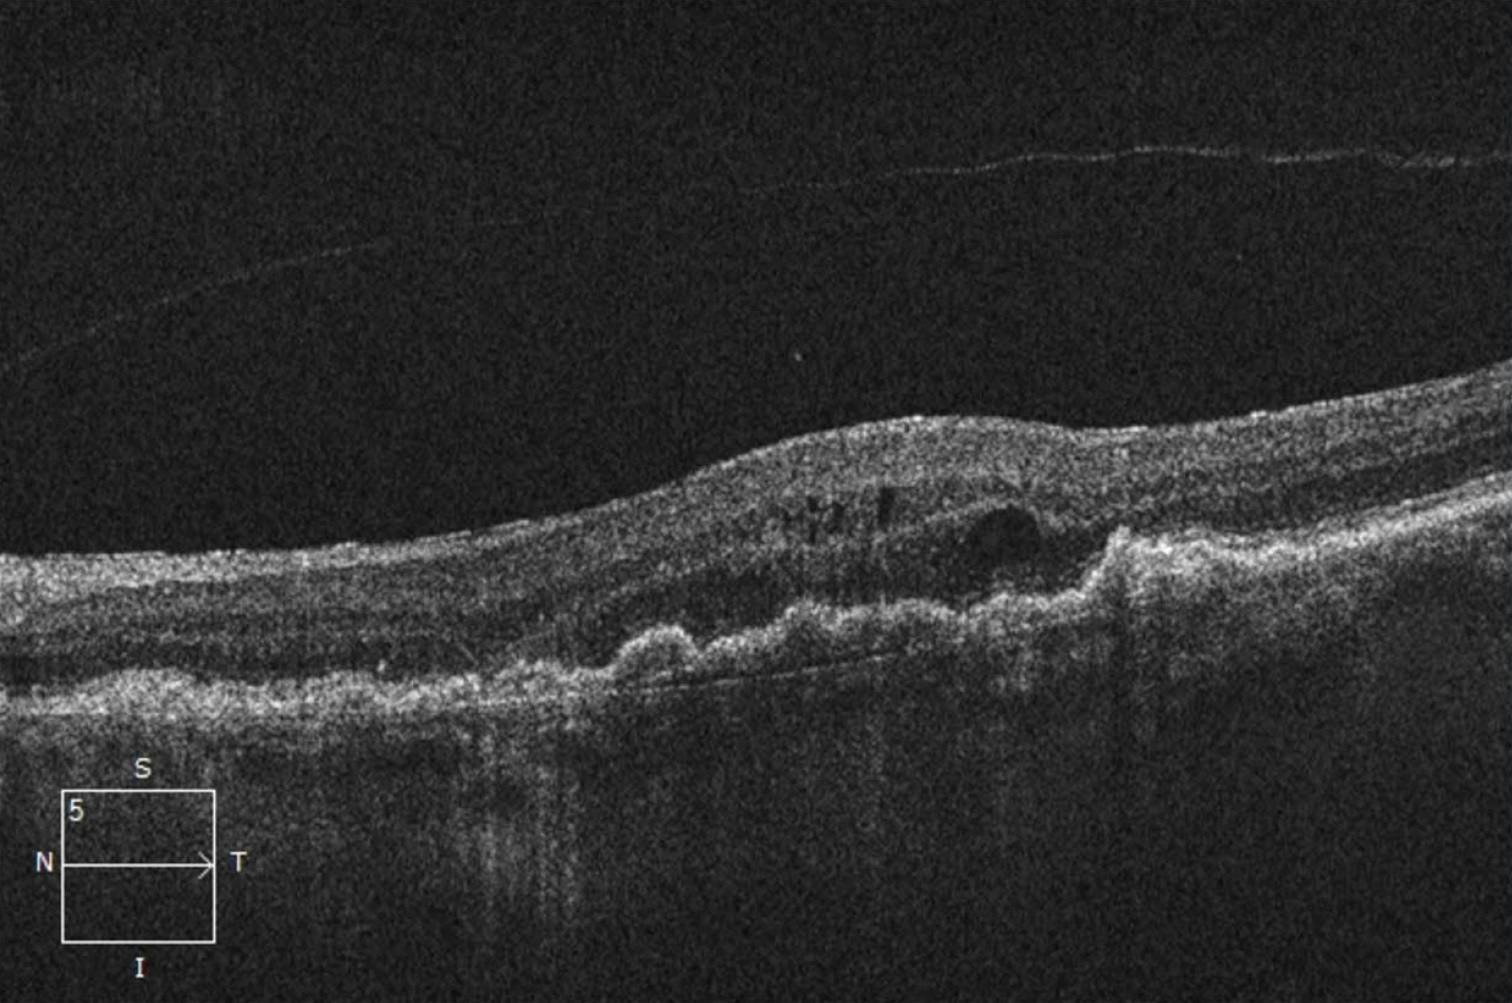
<p>Figure. Patients such as this 74-year-old woman with wet AMD and persistent intraretinal fluid after serial monthly anti-VEGF treatments may be good candidates for treatment with a TKI.</p>

AT A GLANCE
- Tyrosine kinases are signal transduction enzymes that are crucial for various cellular processes, such as cell growth and angiogenesis; tyrosine kinase inhibitors (TKIs) target these pathways.
- Many TKI formulations are being investigated for the treatment of wet AMD using oral, topical, intravitreal, and suprachoroidal delivery methods.
- Encouraging trial data suggest that TKIs may offer a good safety profile while reducing treatment burden, warranting further study in larger clinical trials.
Wet AMD treatment was revolutionized by the advent of anti-VEGF therapy. However, patients may require frequent, even lifelong, injections that are burdensome and may lead to noncompliance (Figure).1 Thus, alternative solutions to improve medication durability and reduce treatment burden are under investigation. Such efforts have included implanted reservoirs, medications targeting multiple signaling pathways, and gene therapies.2 Tyrosine kinase inhibitors (TKIs) have emerged as a promising treatment option for wet AMD. Here, we discuss the mechanisms of TKIs and their potential role in the management of wet AMD.
MECHANISM OF ACTION
TKs are signal transduction enzymes that are crucial for various cellular processes, such as cell growth and angiogenesis. TKIs target these pathways and have been involved in the treatment of various cancers, such as renal cell carcinoma and non-small cell lung cancer.3 Receptor tyrosine kinases (RTKs) are one type of TK located in cell membranes with extracellular and intracellular domains. The extracellular domain binds specific ligands, leading to receptor dimerization, intracellular protein phosphorylation, and downstream signaling cascades responsible for modulating various pathways.
The VEGF receptor (VEGFR) is a specific type of RTK found on the vascular endothelium surface. Anti-VEGF treatments inhibit VEGF from binding to the extracellular VEGFR domains, preventing RTK dimerization, phosphorylation, and subsequent downstream signaling that would otherwise promote angiogenesis.4
In contrast, TKIs act on intracellular domains to inhibit RTK phosphorylation and the subsequent intracellular cascade. TKIs can also target other RTKs in addition to VEGFR, such as platelet-derived growth factor receptor (PDGFR), which may be involved in the pathogenesis of choroidal neovascularization and wet AMD, offering the potential to enhance treatment efficacy and durability.5
CURRENT AND PRIOR EFFORTS
There have been numerous efforts to develop TKI formulations for the treatment of wet AMD, which are well summarized by recently published reviews.5,6 Here, we highlight some notable efforts.
Figure. Patients such as this 74-year-old woman with wet AMD and persistent intraretinal fluid after serial monthly anti-VEGF treatments may be good candidates for treatment with a TKI.
Oral Therapy
Efforts to develop an oral TKI for treating wet AMD have faced challenges. Sorafenib (Bayer), a potent inhibitor of VEGFR 1/2, showed early promise in a small case report; however, no clinical trials are currently underway to investigate further.7 Researchers evaluated pazopanib (Novartis), a non-selective TKI of VEGFR 1/2/3, in an exploratory study that suggested a possible trend for improvement in eyes with low-risk CFH genotypes, but with significant ocular adverse effects (OAEs) and limited results in eyes with high-risk genotypes.8 Vorolanib (X-82; Tyrogenex) was more comprehensively studied in the APEX trial, a phase 2, dose-escalating trial in which patients randomly received placebo or vorolanib. While there was a dose-related reduction in overall injection burden, high dropout rates were observed, possibly related to patients experiencing a high incidence of hepatotoxicity and gastrointestinal side effects.9 These adverse events led to termination of the study.
Topical Options
Trials exploring topical TKIs to treat wet AMD have also shown mixed results. Pazopanib (Novartis), initially tested orally, was investigated topically in a study involving 510 patients. Unfortunately, neither pazopanib monotherapy nor combination therapy with ranibizumab (Lucentis, Genentech/Roche) offered significant therapeutic advantages compared with intravitreal ranibizumab alone.10 Similarly, acrizanib (Adooq Bioscience), which demonstrates inhibitory activity against VEGFR subtypes, failed to adequately control wet AMD activity in a phase 2 trial, with more than 75% of patients requiring rescue injections.11
PAN-90806 (PanOptica), a once-daily topical selective TKI for VEGFR 2, showed promising results in improving BCVA from baseline in select dosage groups.12 However, about 50% of patients still required rescue treatments, limiting its efficacy as a standalone wet AMD maintenance therapy.
Regorafenib (Bayer) was similarly studied in the phase 2a/b DREAM trial, which was terminated due to lower efficacy compared with existing anti-VEGF therapies; post-hoc analyses suggest this may have been due to insufficient drug exposure to the posterior segment.13
One potential medication under investigation is cediranib (AstraZeneca), a TKI targeting all VEGFR isoforms. These nanoparticle eye drops showed promising results in achieving high concentrations in the vitreous and retina of rabbits by using γ cyclodextrin nanoparticles to enhance aqueous solubility without compromising membrane permeability.14 The formulation is awaiting further study in phase 1 human trials.
Intravitreal Approaches
Initial efforts exploring the potential of intravitreal TKIs for wet AMD have shown more promise. Sunitinib malate (GB-102, Graybug Vision), which contains a nonselective TKI with activity against VEGFR 1/2 as well as other RTKs, is an intravitreal depot engineered to degrade over 4 to 6 months. In the phase 2b ALTISSIMO trial, GB-102 demonstrated a notable reduction in treatment burden by 63%, with 48% of patients reaching 6 months without requiring rescue injections.15 However, it was worse at maintaining BCVA with a higher frequency of OAEs compared with aflibercept (Eylea, Regeneron); multiple formulations have been complicated by microparticle migration and aggregation.
Perhaps two of the most promising treatments use novel advances in drug development and delivery platforms.
Vorolanib (Duravyu [formerly EYP-1901], EyePoint Pharmaceuticals) is an intravitreal TKI that inhibits all VEGFR isoforms, PDGFR, and fibroblast growth factor receptors. Vorolanib is delivered via a modified Durasert E insert (EyePoint Pharmaceuticals), which lacks polyimide tubing and a silicone cap, making it fully bioerodible.6,16 In the DAVIO phase 1 trial, vorolanib demonstrated a 77% decrease in treatment burden at 6 months in a small group of patients who required frequent injections.17 In the phase 2 DAVIO 2 trial, patients with previously high injection burden were randomly assigned to aflibercept or vorolanib (low or high dose).18 At 6 months, no treatment-related OAEs were reported, BCVA was noninferior to aflibercept, and treatment burden was reduced by a mean of 85% to 89%, with 64% of patients requiring no supplemental aflibercept.19
Axitinib (OTX-TKI, Ocular Therapeutix) is a hydrogel intravitreal implant that bioresorbs over 8 to 9 months and contains micronized axitinib, a selective inhibitor of VEGFR and PDGFR.6 In a phase 1, dose-escalating trial of 23 patients with active wet AMD in Australia, no OAEs were reported, and 61% of patients (including > 50% of treatment-naïve patients) reached 6 months without rescue injections.20 A separate phase 1b, double-masked US trial of 21 patients with controlled wet AMD and a previously high injection burden showed an 89% reduction in treatment burden at 12 months, with 73% of patients reaching 7 months without rescue injections.21
Suprachoroidal Delivery
Recent suprachoroidal drug delivery systems also offer a unique way to enhance durability and compartmentalization. Axitinib (CLS-AX, Clearside Biomedical) uses the company’s proprietary SCS microinjector to deliver the selective VEGFR/PDGFR inhibitor to the suprachoroidal space.22 The phase 1 OASIS study demonstrated a positive safety profile with stable BCVA and an 81% reduction in treatment burden in anti-VEGF subresponders over 6 months.23 A randomized, double-masked phase 2b trial, ODYSSEY, is currently underway comparing axitinib with an intravitreal aflibercept control arm.24
THE FUTURE OF TKIS
Despite some failures, the future of TKIs for the management of wet AMD is promising. Encouraging clinical trial data suggest that TKIs may offer a good safety profile while reducing treatment burden, warranting further study in larger clinical trials. With continued research and development efforts, we hope that TKIs can one day emerge as a durable treatment augmentation or alternative to existing anti-VEGF therapies, helping providers improve quality of life for patients with AMD.
1. Okada M, Mitchell P, Finger RP, et al. Nonadherence or nonpersistence to intravitreal injection therapy for neovascular age-related macular degeneration: a mixed-methods systematic review. Ophthalmology. 2021;128(2):234-247.
2. Khanani AM, Thomas MJ, Aziz AA, et al. Review of gene therapies for age-related macular degeneration. Eye (Lond). 2022;36(2):303-311.
3. Huang L, Jiang S, Shi Y. Tyrosine kinase inhibitors for solid tumors in the past 20 years (2001-2020). J Hematol Oncol. 2020;13(1):143.
4. Tsujinaka H, Fu J, Shen J, et al. Sustained treatment of retinal vascular diseases with self-aggregating sunitinib microparticles. Nat Commun. 2020;11(1):694.
5. Chandra S, Tan EY, Empeslidis T, Sivaprasad S. Tyrosine kinase inhibitors and their role in treating neovascular age-related macular degeneration and diabetic macular oedema. Eye (Lond). 2023;37(18):3725-3733.
6. Das N, Chaurasia S, Singh RP. A review of emerging tyrosine kinase inhibitors as durable treatment of neovascular age-related macular degeneration. Expert Opin Emerg Drugs. 2023;28(3):203-211.
7. Diago T, Pulido JS, Molina JR, et al. Ranibizumab combined with low-dose sorafenib for exudative age-related macular degeneration. Mayo Clin Proc. 2008;83(2):231-234.
8. McLaughlin MM, Paglione MG, Slakter J, et al. Initial exploration of oral pazopanib in healthy participants and patients with age-related macular degeneration. JAMA Ophthalmol. 2013;131(12):1595-1601.
9. Cohen MN, O’Shaughnessy D, Fisher K, et al. APEX: a phase II randomised clinical trial evaluating the safety and preliminary efficacy of oral X-82 to treat exudative age-related macular degeneration. Br J Ophthalmol. 2021;105(5):716-722.
10. Csaky KG, Dugel PU, Pierce AJ, et al. Clinical evaluation of pazopanib eye drops versus ranibizumab intravitreal injections in subjects with neovascular age-related macular degeneration. Ophthalmology. 2015;122(3):579-588.
11. Poor SH, Weissgerber G, Adams CM, et al. A randomized, double-masked, multicenter trial of topical acrizanib (LHA510), a tyrosine kinase VEGF-receptor inhibitor, in treatment-experienced subjects with neovascular age-related macular degeneration. Am J Ophthalmol. 2022;239:180-189.
12. Chaney P. PAN-90806: once-daily topical anti-VEGF eye drop for wet AMD and other neovascular disease. Paper presented at: Ophthalmology Innovation Summit; San Francisco: 2019.
13. Joussen AM, Wolf S, Kaiser PK, et al. The developing regorafenib eye drops for neovascular age-related macular degeneration (DREAM) study: an open-label phase II trial. Br J Clin Pharmacol. 2019;85(2):347-355.
14. Lorenzo-Soler L, Praphanwittaya P, Olafsdottir OB, et al. Topical noninvasive retinal drug delivery of a tyrosine kinase inhibitor: 3% cediranib maleate cyclodextrin nanoparticle eye drops in the rabbit eye. Acta Ophthalmol. 2022;100(7):788-796.
15. A depot formulation of sunitinib malate (GB-102) compared to aflibercept in subjects with wet AMD (ALTISSIMO). Accessed March 28, 2024. bit.ly/3U1PTwL
16. EyePoint Pharmaceuticals. Investor Presentation: Durasert. Presented September 28, 2022. bit.ly/3PGoUVf
17. Abbey A. The DAVIO trial: a phase 1, open-label, dose-escalation study of a single injection of EYP-1901 (vorolanib in Durasert platform) demonstrating reduced treatment burden in wet age-related macular degeneration. Invest Ophthalmol Vis Sci. 2023;64:931.
18. EyePoint Pharmaceuticals announces positive topline data from the phase 2 DAVIO 2 trial of EYP-1901 in wet AMD achieving all primary and secondary endpoints [press release]. EyePoint Pharmaceuticals. December 4, 2023. Accessed March 28, 2024. bit.ly/3PK6keH
19. Hershberger V. A phase 2, multicenter study of a single injection of EYP-1901 (vorolanib in the Durasert E technology) vs aflibercept for previously treated wet age-related macular degeneration. Presented at: Hawaiian Eye and Retina; January 13-19, 2024; Kuai, Hawaii.
20. Moshfeghi A. Australia-based phase 1 trial of a novel, hydrogel-based, intravitreal axitinib implant for the treatment of neovascular age-related macular degeneration. Presented at: American Academy of Ophthalmology; September 30 - October 3, 2022; Chicago IL.
21. Khanani AM. 12-Month update on randomized, controlled, trial of OTX-TKI (axitinib intravitreal implant) for the treatment of wet AMD. Presented at: Clinical Trials at the Summit; June 10, 2023; Park City, UT.
22. Habot-Wilner Z, Noronha G, Wykoff CC. Suprachoroidally injected pharmacological agents for the treatment of chorioretinal diseases: a targeted approach. Acta Ophthalmol. 2019;97(5):460-472.
23. Clearside Biomedical. Investor Presentation: OASIS phase 1/2a clinical trial results. Presented November 9, 2022. Accessed March 28, 2024. bit.ly/3TEcJcE
24. Study to evaluate suprachoroidally administered CLS-AX in the treatment of neovascular age-related macular degeneration (ODYSSEY). Accessed April 3, 2024. bit.ly/3U1Rdj





























